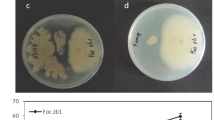

Abstract
Fusarium proliferatum was isolated as a major pathogen causing the Fusarium disease in harvested banana fruit. One of its major compounds, fusaric acid, was identified by high-performance liquid chromatography–electrospray ionization mass spectrometry (HPLC–ESI–MS). Because the light intensity of the luminescent bacterium Vibrio qinghaiensis sp. Nov. Q67 can be inhibited by fusaric acid, the fusaric acid content of F. proliferatum was assessed and compared by both the HPLC and luminescent bacterium methods. Although both methods afforded almost similar values of fusaric acid, the latter indicated slightly lower content than the former. Czapek medium was more suitable for the growth of F. proliferatum and fusaric acid production than modified Richard medium, with an optimum pH of approximately 7.0. However, no significant (P < 0.05) correlation was obtained between the fusaric acid production and growth of mycelia of F. proliferatum. The study suggests that the bioevaluation by use of the luminescent bacterium was effective in monitoring fusaric acid production by F. proliferatum without expensive equipment.
Similar content being viewed by others
Explore related subjects
Discover the latest articles, news and stories from top researchers in related subjects.Avoid common mistakes on your manuscript.
Introduction
Fusarium proliferatum is a fungal pathogen found all over the world. It has been reported as a pathogen of a number of crops, fruit, and vegetables, for example maize [1], rice [2, 3], asparagus [4], banana [5], mango [6], date palm [7], Allium fistulosum [3], onion, and garlic [2]. This pathogen is known to produce a series of toxic secondary metabolites, for example fumonisins, moniliformin, beauvericin, fusaproliferin, fusaric acid, and bikaverin [2–4, 8], depending on its different strains and/or culture media. For example, Jiménez and Mateo reported that F. proliferatum isolated from banana fruit could yield a large amount of fumonisin B1, rather than other mycotoxins, in corn and rice cultures [11]. However, F. proliferatum isolated from banana skin produced a large amount of fusaric acid (5-butylpicolinic acid) in Czapek culture in our preliminary study.
Fusaric acid is a well-known phytotoxin which triggers wilt disease in different plants [9]. Moreover, it is a mycotoxin with low to moderate toxicity and synergistic effects with other mycotoxins [10]. Current methods for analysis of fusaric acid commonly involve UV spectrophotometry, high-performance liquid chromatography (HPLC), high-performance liquid chromatography–electrospray ionization mass spectrometry–mass spectrometry (HPLC–ESI–MS–MS) and gas chromatography–mass spectrometry (GC–MS) [7, 12]. Although the UV method is simple, it usually requires a complex preparation procedure for sample extraction and clean-up. In addition, fusaric acid at a low level cannot be detected because of poor recovery during sample treatment or a relatively low instrumental sensitivity. In contrast, chromatographic methods, for example HPLC–ESI–MS and GC–MS are highly sensitive, but are expensive. In addition, it is difficult to evaluate accurately the hazard of mycotoxin contamination of food and animal feed because of interference from other toxic chemicals [13]. Therefore, it is necessary to develop a simple, reproducible and inexpensive method for detection of secondary metabolites, particularly the fusaric acid produced by the pathogen.
Bioassays have become increasingly useful for mycotoxin detection as an alternative to chemical analysis. One of these rapid and cost-effective methods for testing potential toxicity is the Microtox assay system [14], which, in fact, measures the decrease in light emission by the luminescent bacterium Vibrio fischeri after contact with toxic compounds. However, use of the Microtox assay has an obvious limitation because it is operated in a very narrow pH range (pH 6.5−7.5) and requires an additional 2−3% sodium chloride [15], which is believed to be able to interfere with the inherent properties of some samples [16–18]. Therefore, the effectiveness of this luminescence bioassay is restricted and needs to be improved.
A fresh water luminescent bacterium Vibrio qinghaiensis sp. Q67 has been extensively used, with much experimental reliability and effectiveness, to assess the potential toxicity of different types of chemical pollutant [19–22]. Moreover, this freshwater bacterium tolerates a wide range of pH and is luminescent in fresh water [23]. Use of V. qinghaiensis sp. Q67 to evaluate the toxicity of secondary metabolites produced by microorganisms has therefore been suggested.
Fresh fruit after harvest is very perishable because of infection by pathogens. Banana is an important economic fruit throughout the world, but deteriorates easily owing to rot development caused by infection with post-harvest pathogens, for example F. proliferatum. Because fusaric acid is a characteristic compound produced by F. proliferatum, the objective of this study was to identify fusaric acid by HPLC–ESI–MS then use the luminescent bacterium V. qinghaiensis sp. Q67 to estimate the amount of fusaric acid produced by F. proliferatum in different culture media, at different pH, and with different incubation time, and finally compare the aforementioned two methods for measurement of fusaric acid. This study can also help develop a novel luminescent bacterium method for monitoring the potential toxicity of secondary metabolites produced by fungi.
Experimental
Isolation and culture of fungus
Decayed banana fruit were collected and cut into 3-mm pieces which were dipped into 75% ethyl alcohol for 5–10 s, sterilized with 0.1% HgCl2 solution for 1 min, washed three times with sterile distilled water, and then placed into potato dextrose agar (PDA) medium in 90-mm Petri dishes. After incubation for 5 days at 28 °C, agar pieces with mycelia were taken from colony edge and transferred to the PDA plates for incubation at 25 °C. A pure strain was obtained and identified as Fusarium proliferatum by Guangdong Detection Center of Microbiology, Guangzhou, China.
Czapek medium consisted of 2 g NaNO3, 1 g KH2PO4, 0.5 g KCl, 0.5 g MgSO4·7H2O, 0.01 g FeSO4, and 30.0 g sucrose, in a total volume of 1000 mL distilled water; modified Richard’s medium comprised 10 g KNO3, 5 g KH2PO4, 2.5 g MgSO4·7H2O, 0.02 g FeSO4, and 50.0 g sucrose, in a total volume of 1000 mL distilled water. Potato dextrose bouillon was made by boiling 1000 mL distilled water containing 200 g potato for 30 min. The slurry was then filtered through a double layered muslin cloth before addition of 20 g dextrose. Potato sucrose bouillon was also made by using 20 g of sucrose instead of 20 g of dextrose in the potato dextrose bouillon. Corn culture-medium (20%, w/v) was prepared by boiling 1000 mL distilled water containing 200 g dry corn powder for 60 min. The mixture was then filtered through a double layered muslin cloth and the final volume was diluted to a total volume of 1000 mL.
Frozen powder of the luminescent bacterium V. qinghaiensis sp. Nov. Q67 was obtained from Beijing Hamamatsu Photon Technology (Beijing, China). The culture medium consisted of 13.6 mg KH2PO4, 35.8 mg Na2HPO4·12H2O, 0.25 g MgSO4·7H2O, 0.61 g MgCl2·6H2O, 33.0 mg CaCl2, 1.34 g NaHCO3, 1.54 g NaCl, 5.0 g yeast extract, 5.0 g tryptone, and 3.0 g glycerin in a total volume of 1000 mL distilled water.
Extraction of secondary metabolites from F. proliferatum
Extraction of secondary metabolites was carried out in accordance with the methods of Wu et al. [9] and Jurado et al. [24], with some modifications. Czapek medium (100 mL) was placed in a conical flask, autoclaved at 121 °C for 20 min, then cooled naturally to room temperature. The broth in the conical flask was inoculated with mycelia disks of F. proliferatum. Cultures were incubated at 28 °C for 10 days with 12 h illumination every day in an orbital shaker (150 rpm). The resulting broth was adjusted to pH 2 with 2 mol L−1 HCl and then extracted five times with ethyl acetate to obtain the metabolite extract. To obtain the dry extract the solvent was removed by rotary evaporation at 40 °C under vacuum. The dried residue was dissolved in 5 mL methanol then filtered through a 0.45-μm Millipore membrane filter before HPLC–ESI–MS analysis.
Identification of fusaric acid by HPLC–ESI–MS
The secondary metabolites produced by F. proliferatum were detected by use of HPLC–ESI–MS–MS (Agilent, USA, 1100 Esquire HCTplus) with an Eclipseplus C18 column (150 mm × 2.1 mm i.d., 5 μm particle size; Agilent, USA) using a binary mobile phase gradient prepared from 0.1% trifluoroacetic acid as component A and acetonitrile as component B [9, 25]. The HPLC conditions were: isocratic step at 10% solvent B for 3 min followed by a linear gradient to 100% solvent B for 25 min, with a flow rate of 0.2 mL min−1. The sample injection volume was 5 μL. The general ESI–MS–MS conditions, adopted from the method described by Yamashita et al. [26] were: spray voltage, +4500 V; sheath gas (nitrogen) pressure, 30 arbitrary units; collision gas argon, 1.5 mTorr; auxiliary gas (nitrogen) pressure, 15 arbitrary units; and ion transfer capillary temperature, 350 °C. The mass spectrometer was run in the full-scan mode, and the fragments were detected over m/z 50−400 scan range. The targeted protonated molecular ion was 180 ([M + H]+) (Fig. 1a). For quantification of fusaric acid produced by F. proliferatum, fusaric acid standard was purchased from Sigma–Aldrich to prepare an external calibration plot which was linear in the range 0.1−2 mg mL−1 (Fig. 2).
Determination of fusaric acid content by use of V. qinghaiensis sp. Nov. Q67
Determination of fusaric acid content was carried out by the method of Ma et al. [23], with some modifications. Before each test, the relative light unit (RLU) of V. qinghaiensis sp. Nov. Q67 was adjusted to 50,000 − 300,000 by adding 0.8% NaCl solution. The assay was carried out by adding 0.1 mL bacterial suspension and 0.9 mL 0.8% NaCl test solution into a glass vessel. After thorough mixing of the mixture, the initial RLU was recorded by use of a luminometer (BPCL-16Y Ultra-Weak Luminescence Analyzer, Institute of Biophysics, Chinese Academy of Sciences, Beijing, China). The final RLU was recorded at 5-min intervals at 22 ± 1 °C. Standard fusaric acid at five concentrations (5, 10, 20, 30, and 40 μg mL−1) in 0.8% NaCl solution was prepared; 0.8% NaCl solution was used as control. The inhibition (E) induced by the fusaric acid against V. qinghaiensis sp. Nov. Q67, was expressed by the formula: E (%) = (I 0 − I)/I 0 × 100, where I 0 and I were the averages of the RLU of V. qinghaiensis sp. Nov. Q67 exposed to the control and test solutions, respectively. The calibration curve was linear in the range 5−40 μg mL−1 fusaric acid standard (Fig. 3).
Fusaric acid production by F. proliferatum
Different culture media, i.e., Czapek medium, modified Richard medium, potato dextrose bouillon, potato sucrose bouillon, and corn culture-medium were tested in the production of fusaric acid by F. proliferatum. The initial pH of the Czapek medium was adjusted to 3.0−10.0 with 1 mol L−1 HCl or NaOH. After 10 days of culture of F. proliferatum in these media, fusaric acid was extracted by the aforementioned method and mycelia were collected. To investigate the effect of culture time, Czapek medium was used to collect mycelia every 5 days and fusaric acid was extracted and analyzed by both the HPLC and luminescent bacterium methods. Mycelia were collected by filtration through Whatman (UK) No. 1 paper, then dried in an oven overnight and finally weighed as a growth indicator [27]. All the experiments were performed in triplicate.
To evaluate the recovery of the luminescent bacterium assay after 10 days of culture of F. proliferatum in Czapek medium, samples were spiked with 0 or 2 mg mL−1 standard fusaric acid. Fusaric acid was then extracted, dried, and analyzed by the luminescent bacterium method as mentioned above, to evaluate the recovery. The experiment was repeated three times.
Data analysis
Results for each variable were analyzed statistically by use of SPSS version 16.0 (SPSS, Chicago, USA). The mean values were compared using two-tailed t-tests at P < 0.05.
Results and discussion
Identification of fusaric acid
Fusarium proliferatum is a major pathogen of harvested banana fruit. Jiménez and Mateo reported that F. proliferatum isolated from decayed banana fruit can yield a large amount of fuminosin B1 but did not produce other mycotoxins in corn and rice cultures [11]. Some reports have shown that one strain of F. proliferatum can produce different mycotoxins in different cultures [1–8]. Fusaric acid could be produced by some Fusarium species, including F. proliferatum [10]. In this study, F. proliferatum isolated from decayed banana fruit was found to be able to produce a large amount of fusaric acid. Figure 1 shows the HPLC–MS chromatograms obtained from fusaric acid standard and from the ethyl acetate extract of Czapek culture filtrate of F. proliferatum. HPLC–MS analysis showed a peak of fusaric acid standard at a retention time of 5.50 min (Fig. 1a). A similar peak of the Czapek culture filtrate was observed at 5.48 min (Fig. 1b). Both peaks had a molecular ion [M + H]+ at m/z 180 and the major fragment ion at m/z 152 in their positive ESI–MS spectra, in agreement with spectra of fusaric acid previously reported by Son et al. [28]. Thus, the presence of fusaric acid in the ethyl acetate extract of Czapek culture filtrate was confirmed on the basis of the same retention time and ion profile. The linear relationship between peak area and concentration of fusaric acid was represented by the equation y = 11040000x + 1057000, with a correlation coefficient (R 2) of 0.9839 (Fig. 2).
Amalfitano et al. [29] developed a simple and rapid HPLC method using a high-density C18 column for quantitative analysis of fusaric and dehydrofusaric acids and their methyl esters in methanol extracts from lyophilized culture filtrates of Fusarium species. In that method, methanol, water, and 1% dipotassium hydrogen phosphate buffer at pH 7.35 were used as mobile phase. In this study, it was found that fusaric acid could be rapidly separated by use of trifluoroacetic acid and acetonitrile as mobile phase, which has an advantage of avoiding precipitation of inorganic salts in the column and detector. In general, the HPLC–MS analysis is regarded as a desirable method for identification of fusaric acid, despite its instrumental cost.
Evaluation of the biological toxicity of fusaric acid by use of V. qinghaiensis sp. Nov. Q67
The effect of fusaric acid on the light intensity of the luminescent bacterium V. qinghaiensis sp. Nov. Q67 is shown in Fig. 4. The relative light intensity of V. qinghaiensis sp. Nov. Q67 was highly dependent on fusaric acid concentration and incubation time. Increasing the concentration of fusaric acid significantly enhanced inhibition of light emission by the luminescent bacterium. Inhibition by fusaric acid of the intensity of light emitted by V. qinghaiensis sp. Nov. Q67 generally increased with increasing incubation duration up to 45 min, although it did not increase substantially after 15 min. Thus, an incubation time of 15 min was selected for this bioassay. The concentration resulting in 50% inhibition of the light intensity of the luminescent bacterium (EC50) was 16.50 μg mL−1 (Fig. 3). Furthermore, it was found that recovery in the luminescent bacterium method was satisfactory—in the range 86.5–91.9%, with a mean recovery of 88.9%.
Bacteria as indicators have been widely used to assess the overall toxicity of chemicals, commercial products, and environmental pollution [30, 31]. Kratasyuk et al. [32] investigated the effects of mycotoxins on NADH:flavine mononucleotide oxidoreductase–luciferase by use of a bacterial bioluminescence system. The sensitivity of the bioluminescence system in response to mycotoxins decreased in the order (based on the EC50 values obtained): zearalenone > deoxynivalenol > toxin T-2 > diacetoxiscripenol. Bacterial bioluminescence assay can also be used to evaluate the acute toxicity of beauvericin, which was found to have a moderate EC50 value of 94 ± 9 μg mL−1 [33]. Katsev et al. [34] investigated the acute and chronic toxicity of T-2 by the bioluminescent method using two strains of luminescent bacteria, Photobacterium phosphorum Sq3 and Vibrio fischeri F1; EC50 values of 12 mg mL−1 after incubation for 10 min were obtained in the acute experiment and 18 mg mL−1 after incubation for 16 h in the chronic experiment. This study also revealed that the freshwater luminescent bacterium system can also be used to evaluate the overall acute toxicity of fusaric acid in the range 5−50 μg mL−1, with a lower EC50 (16.50 mg−1) than for use of T-2, in an agreement with previous reports of the antibacterial activity of fusaric acid [28, 35].
Effects of culture media on fusaric acid production by F. proliferatum
Because fusaric acid from F. proliferatum has been found naturally in maize, wheat, rice, and their products, it is necessary to understand the effect of culture media on fusaric acid production in an effort to prevent its contamination of foods [10, 12, 36]. F. moniliforme and F. proliferatum isolated from maize had similar growth rates and were able to produce fumonisin B1 in irradiated maize grain [1]. The growth of F. proliferatum and the production of fusaric acid in different culture media are listed in Table 1. It was observed that F. proliferatum could produce fusaric acid in both Czapek medium and modified Richard medium, but the former was better than the latter for fusaric acid production. The fusaric acid content of the Czapek and modified Richard culture media on the 10th day were analyzed by HPLC with the results 156.79 and 67.35 mg L−1, respectively. In contrast , no fusaric acid was detected in corn culture-medium, although this was the optimum choice for growth of F. proliferatum mycelium. The effects of different pH on growth of F. proliferatum mycelium and production of fusaric acid in Czapek medium are listed in Table 2. It was apparent that initial pH strongly affected fusaric acid production, with the maximum amount being obtained at pH 7.0. Growth of F. proliferatum mycelium increased in the pH range from 3.0 to 6.0, but decreased at pH values between 7.0 and 8.0, and increased again at pH values between 9.0 and 10.0. The optimum pH for fusaric acid production was determined to be 7.0 in Czapek medium for 10 days. As shown in Table 3, production of fusaric acid in this medium by F. proliferatum increased sharply from the 5th day to the 10th day, then increased slightly and finally reached a maximum on the 25th day, when cell mass accumulation of F. proliferatum, as indicated by estimation of the dry weight, also reached a maximum. Compared with the results obtained by HPLC analysis, the fusaric acid content detected by the V. qinghaiensis sp. Nov. Q67 test was slightly lower, but both methods gave similar analytical trends in fusaric acid analysis (Tables 1–3). On the basis of the requirement to develop a bioassay with a rapid, simple, and cost-effective procedure, the bioluminescence assay using V. qinghaiensis sp. Nov. Q67 was found suitable for estimation of the amount of fusaric acid produced by F. proliferatum.
Environmental conditions can greatly affect the growth of fungi in crops and production of mycotoxins [37–40]. Keller et al. [27] reported that oxygen and pH can affect the growth of F. proliferatum and the production of fumonisin B1. For example, the F. proliferatum produced less FB1 at pH > 5.0, and an adequate supply of oxygen could increase mycelium growth and FB1 production. These results indicated no significant correlation between mycotoxin production and mycelium dry weight.
Conclusions
This study identified fusaric acid, a fungal pathogen of banana fruit, produced by Fusarium proliferatum. Czapek medium was more suitable for mycelium growth and fusaric acid production than modified Richard medium. The optimum pH for fusaric acid production was approximately 7.0. On the basis of the bioassay using the luminescent bacterium V. qinghaiensis sp. Nov. Q67, fusaric acid had high biological toxicity with an EC50 of 16.50 μg mL−1. Compared with the HPLC method, the fusaric acid content detected by V. qinghaiensis sp. Nov. Q67 was slightly lower, but similar trends was obtained in analysis of fusaric acid content. The luminescent bacterium method required a relatively short time (approx. 30 min for extraction, 45 min for drying, and 15 min for analysis), however. As a result, the luminescent bacterium method is regarded as an appropriate, effective, and simple method which can be used as an alternative for monitoring fusaric acid production by F. proliferatum without expensive equipment. Furthermore, bioevaluation of the total toxicity caused by other mycotoxins in the contaminated foods and feedstuffs can also be achieved by use of this bio-luminescent bacterial system.
References
Marín S, Magan N, Serra J, Ramos AJ, Canela R, Sanchis V (1999) Fumonisin B1 production and growth of Fusarium moniliforme and Fusarium proliferatum on maize, Wheat, and Barley Grain. J Food Sci 64:921–924
Stankovic S, Levic J, Petrovic T, Logrieco A, Logrieco A, Moretti A (2007) Pathogenicity and mycotoxin production by Fusarium proliferatum isolated from onion and garlic in Serbia. Eur J Plant Pathol 118:165–172
Dissanayake MLMC, Tanaka S, Ito S (2009) Fumonisin B1 production by Fusarium proliferatum strains isolated from Allium fistulosum plants and seeds in Japan. Lett Appl Microbiol 485(5):598–604
Seefelde W, Gossmann M, Humpf HU (2002) Analysis of fumonisin B1 in Fusarium proliferatum-infected asparagus spears and garlic bulbs from Germany by liquid chromatography - Electrospray ionization mass spectrometry. J Agric Food Chem 50:2778–2781
Anthony S, Abeywickrama K, Dayananda R, Wijeratnam SW, Arambewela L (2004) Fungal pathogens associated with banana fruit in Sri Lanka, and their treatment with essential oils. Mycopatholo 157:91–97
Zhan RL, Yang SJ, Ho HH, Liu F, Zhao YL, Chang JM, He YB (2010) Mango Malformation Disease in South China Caused by Fusarium proliferatum. J Phytopathol 158:721–725
Abdalla MY, Al-Rokibah A (2000) Pathogenicity of toxigenic Fusarium proliferatum from date palm in Saudi Arabia. Plant Dis 84:321–324
Kohut G, Oláh B, Ádám AL, García-Martínez J, Hornok L (2010) Adenylyl cyclase regulates heavy metal sensitivity, bikaverin production and plant tissue colonization in Fusarium proliferatum. J Basic Microbiol 50:59–71
Wu HS, Yin XM, Liu DY, Ling N, Bao W, Ying RR, Zhu YY, Guo SW, Shen QR (2008) Effect of fungal fusaric acid on the root and leaf physiology of watermelon (Citrullus lanatus) seedlings. Plant Soil 308:255–266
Bacon CW, Porter JK, Norred WP, Leslie JF (1996) Production of fusaric acid by Fusarium species. Appl Environ Microbiol 62:4039–4043
Jiménez M, Mateo R (1997) Determination of mycotoxins produced by Fusarium isolates from banana fruits by capillary gas chromatography and high-performance liquid chromatography. J Chromatogr A 778:363–372
Bacon CW, Hinton DM, Porter JK, Glenn AE, Kuldau G (2004) Fusaric acid, a Fusarium verticillioides metabolite, antagonistic to the endophytic biocontrol bacterium Bacillus mojavensis. Can J Bot 82:878–885
Smith TK, Sousadias MG (1993) Fusaric acid content of swine feedstuffs. J Agric Food Chem 41:2296–2298
Bulich AA (1979) Use of luminescent bacteria for determining toxicity in aquatic environments. In: Markings LL, Kimerle RA (eds) Aquatic Toxicology, STP 667. American Society for Testing and Materials, Philadelphia, pp 98–106
Tarkpea M, Hansson M, Samuelsson B (1986) Comparison of the microtox test with the 96Hr LC50 test for the Harpacticoid Nitocra spinipes. Ecotoxicol Environ Saf 11:127–143
Vasseur P, Bios F, Ferard JF, Rast C, Larbaiyt G (1986) Influence of physicochemical parameters on the Microtox test response. Environ Toxicol 1:283–300
Hinwood AL, McCormik MJ (1987) The effect of ionic solutes on EC50 values measured using the Microtox test. Environ Toxicol 2:449–461
Ankley GT, Hoke RA, Giesy JP, Winger PV (1989) Evaluation of the toxicity of marine sediments and dredge spoils with the Microtox Bioassay. Chemosphere 18:2069–2075
Shen KL, Shen CF, Lu Y, Tang XJ, Zhang CK, Chen XC, Shi JY, Lin Q, Chen YX (2009) Hormesis response of marine and freshwater luminescent bacteria to metal exposure. Biol Res 42:183–187
Zhang J, Liu SS, Liu HL (2009) Effect of ionic liquid on the toxicity of pesticide to Vibrio-qinghaiensis sp.-Q67. J Hazar Mater 170:920–927
Zhao HM, Zhang CY, Ge ZG, Wang ZY (2010) Toxicity measurement of the fluorobenzene derivants against Vibrio Qinghaiensis (Q67) and their 2D, 3D-QSAR study. Chin J Struct Chem 29:1467–1476
Zhou XF, Sang WJ, Liu SS, Zhang YL, Ge HL (2010) Modeling and prediction for the acute toxicity of pesticide mixtures to the freshwater luminescent bacterium Vibrio qinghaiensis sp. -Q67. J Environ Sci 22:433–440
Ma M, Tong Z, Wang Z, Zhu W (1999) Acute toxicity bioassay using the freshwater luminescent bacterium Vibrio qinghaiensis sp. Nov.-Q67. Bull Environ Contam Toxicol 62:247–253
Jurado M, Marín P, Callejas C, Moretti A, Vázquez C, González-Jaén MT (2010) Genetic variability and Fumonisin production by Fusarium proliferatum. Food Microbiol 27:50–57
Venter SL, Steyn PJ, Steyn HSF (1996) Production of fusaric acid by Fusarium oxysporum. Potato Res 39:79–84
Yamashita K, Yamazaki K, Komatsu S, Numazawa M (2010) Fusaric acid as a novel proton-affinitive derivatizing reagent for highly sensitive quantification of hydroxysteroids by LC-ESI-MS/MS. J Am Soc Mass Spectrom 21:249–253
Keller SE, Sullivan TM, Chirtel S (1997) Factors affecting the growth of Fusarium proliferatum and the production of fumonisin B1, oxygen and pH. J Ind Microbiol Biotechnol 19:305–319
Son SW, Kim HY, Choi GJ, Lim HK, Jang KS, Lee SO, Lee S, Sung ND, Kim JC (2008) Bikaverin and fusaric acid from Fusarium oxysporum show antioomycete activity against Phytophthora infestans. J Appl Microbiol 104:692–698
Amalfitano C, Pengue R, Andolfi A, Vurro M, Zonno MC, Evidente A (2002) HPLC analysis of fusaric acid, 9,10–dehydrofusaric acid and their methyl esters, toxic metabolites from weed pathogenic Fusarium species. Phytochem An 13(5):277–282
Froehner K, Meyer W, Grimme LH (2002) Time-dependent toxicity in the long-term inhibition assay with Vibrio fisheri. Chemosphere 46:987–997
Peinado MT, Mariscal A, Carnero-Varo M, Fernandez-Crehuet J (2002) Correlation of two bioluminescence and one fluorogenic bioassay for the detection of toxic chemicals. Ecotoxicol Environ Saf 53:170–177
Kratasyuk VS, L’Vova LS, Egorova OI, Kudryasheva NS, Orlova NYu, Bytev VO (1998) Effect of Fusarium mycotoxins on a bacterial bioluminescence system in vitro. Appl Biochem Microbiol (Prikladnaya Biokhimiya i Mikrobiologiya) 34:207–209
Fotso J, Smith JS (2003) Evaluation of beauvericin toxicity with the bacterial bioluminescence assay and the Ames mutagenicity bioassay. J Food Sci 68:1938–1941
Katsev AM, Goister OS, Starodub NF (2003) Mycotoxin T–2 effect on intensity of bacteria bioluminescence. Ukr Biokhim Zh 75(3):99–103
Meca G, Sospedra I, Soriano JM, Ritieni A, Moretti A, Mañes J (2010) Antibacterial effect of the bioactive compound beauvericin produced by Fusarium proliferatum on solid medium of wheat. Toxicon 56:349–354
Pascale M, Visconti A, Avantaggiato G, Prończuk M, Chelkowski J (1999) Mycotoxin contamination of maize hybrids after infection with Fusarium proliferatum. J Sci Food Agric 79:2094–2098
Charmley LL, Rosenber A, Trenholm HL (1994) Factors responsible for economic losses due to Fusarium mycotoxin contamination of grains, foods and feedstuffs. In: Miller JD, Trenholm HL (eds) Mycotoxins in Grain: Compounds Other Than Aflatoxin. Eagan Press, Minnesota, pp 471–486
Pose G, Patriarca A, Kyanko V, Pardo A, Fernández Pinto V (2010) Water activity and temperature effects on mycotoxin production by Alternaria alternata on a synthetic tomato medium. Int J Food Microbiol 142:348–353
Tirado MC, Clarke R, Jaykus LA, McQuatters-Gollop A, Frank JM (2010) Climate change and food safety: A review. Food Res Int 43:1745–1765
Hollinger K, Ekperigin HE (1999) Mycotoxicosis in food producing animals. Vet Clin North Am Food Anim Pract 15:133–165
Acknowledgements
This work was supported by the National Natural Science Foundation of China (grant no. 30928017), the CAS/SAFEA International Partnership Program for Creative Research Teams and the 5th China-South African Joint Research Program (grant no. CS05-L08) by the Ministry of Science and Technology, China.
Author information
Authors and Affiliations
Corresponding author
Rights and permissions
About this article
Cite this article
Li, J., Jiang, G., Yang, B. et al. A luminescent bacterium assay of fusaric acid produced by Fusarium proliferatum from banana. Anal Bioanal Chem 402, 1347–1354 (2012). https://doi.org/10.1007/s00216-011-5546-6
Received:
Revised:
Accepted:
Published:
Issue Date:
DOI: https://doi.org/10.1007/s00216-011-5546-6